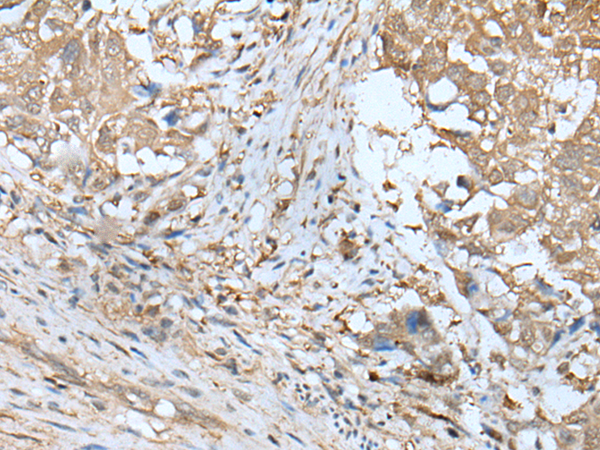
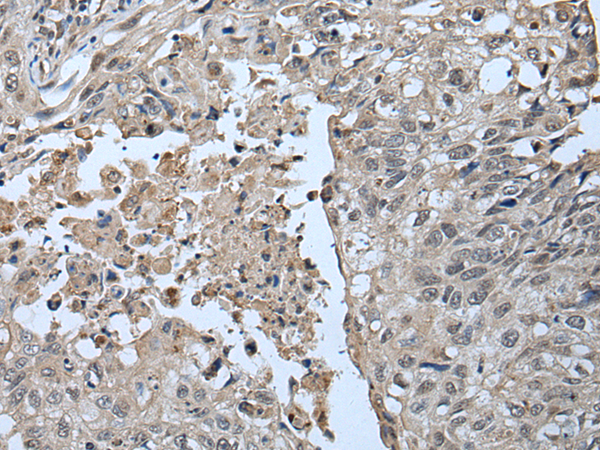

-
分类: 科研抗体货号: P09291别名: AMACO; NET42; CCSP-2应用: IHC反应种属: Human
-
分类: 科研抗体货号: P09296别名: THIFP1; UBE1DC1应用: WB,IHC反应种属: Human, Mouse, Rat
-
分类: 科研抗体货号: P09290别名: MMDS3; MVti1; VTI1RP2; Vti1-rp2应用: WB,IHC反应种属: Human, Mouse
-
分类: 科研抗体货号: P09295别名: AGX; AGX1; AGX2; SPAG2应用: WB,IHC反应种属: Human
-
分类: 科研抗体货号: P09289别名: PPD; KTCN; PPCD; RINX; KTCN1; PPCD1; CAASDS应用: IHC反应种属: Human
-
分类: 科研抗体货号: P09294别名: U2AF65应用: IHC反应种属: Human, Mouse
-
分类: 科研抗体货号: P09288别名: 8HS20; N27C7-2应用: IHC反应种属: Human
-
分类: 科研抗体货号: P09317别名: BM-002; C13orf20应用: IHC反应种属: Human, Mouse, Rat
-
分类: 科研抗体货号: P09315别名: C6orf133; bA49A4.1; dJ242G1.1; dJ392M17.3应用: IHC反应种属: Human, Mouse
-
分类: 科研抗体货号: P09314别名: UIP5; RNF37; hUIP5; UBCE7IP5应用: WB,IHC反应种属: Human

鄂公网安备42018502007531号
鄂公网安备42018502007531号

